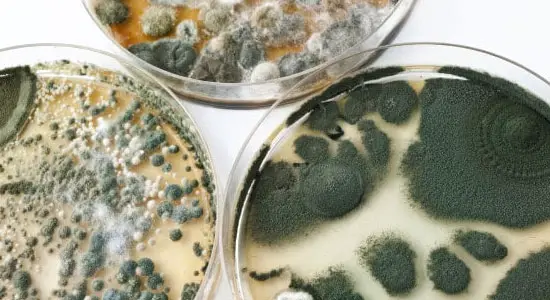

Do you want to know what black mold symptoms are? This type of fungi, also known as Stachybotrys chartarum, can cause health problems, although human exposure does not always result in ill effects. The nature and severity of the health problems depends on each person’s relative state of health and the amount of time they are exposed to the mold. Immune compromised individuals and small children can suffer much more severe effects from exposure than a normal, healthy adult. Similarly, those individuals who either work or live for concentrated periods of time next to black mold are more likely to develop symptoms than those who only come into brief contact.
Mycotoxins and toxicity
In of itself, mould poses no harmful effects to humans. Some quantity is always present in the air. Mould grows seasonally outdoors, and tends to grow in humid, dark indoor environments, such as near sinks, drains, and faucets.
Mold is generally only dangerous if it produces what are known as “mycotoxins”. Mycotoxins are capable of producing ill-effects in vertebrates.
However, even if mold is capable of producing mycotoxins, it may or may not actually produce them, depending on complex environmental factors which are not totally understood. Therefore, the simple appearance of black mold does not automatically mean that toxins are present. The mildew must be tested to concretely determine if it is producing mycotoxins.
According to the CDC mold sampling and testing is often unreliable and does not determine the health risks involved. In general, large clumps of any type of mould should be removed when they are first identified, and be treated as possible contaminants.
When a person approaches mold, he should protect his respiratory tract and skin by wearing appropriate safety equipment. At no time should he purposefully inhale or ingest the mildew.
Inhalation vs. ingestion
Mold can be ingested or inhaled. The effects of ingested mold are easy to quantify. However, there is no currently no single “biomarker” that allows scientists to verify with complete certainty that a person has inhaled the mildew.
A biomarker is the presence in the body of a particular chemical generated from exposure to a given substance.
The health effects from mold inhalation, therefore, are much more difficult to accurately categorize and identify. Because of this unclear identification process, there are no regulations on what constitutes a “safe” or “unsafe” level of mold.
Exposure levels
Despite the lack of clearly defined regulations, there are a few general guidelines which people should follow to avoid endangering themselves or their children. No one should inhabit a chronically water-damaged environment such as a building or other indoor space (f.e. a bedroom). Constant exposure to this type of environment can lead to health problems, especially for infants under the age of 6 months.
An immune-compromised person may only need the briefest exposure to black mold in order to manifest health problems. A healthy adult may manifest absolutely no symptoms until after years of exposure. Because each person reacts differently, there is no set limit as to how long a person can be safely exposed to mold.
Mold is generally the most dangerous if it can be seen with the naked eye, or smelled. If an individual can spot a large clump of mould, that person should immediately remove themselves from the environment and seek medical attention. However, small amounts of the fungi, such as those that may appear on a shower wall, are not generally to be considered to be dangerous, and be cleaned using materials found around the house.
How much mold exposure is harmful?
While there is no magic number for how much black mold you need to be exposed to before it poses health risks, no level of contact is truly “healthy,” and you should take steps to avoid or limit your exposure. Every person’s body reacts differently, and some individuals may have a higher “tolerance” before exhibiting symptoms of harmful exposure.
If you suspect you were exposed to black mold, look at the symptoms below and contact your physician if you’re experiencing any of them.
Black mold health effects
What are the specific black mold health effects? While the list below lists the most commonly reported symptoms of those who have inhaled mould, each individual may react to mold exposure in their own way.
Asthma
There is no proof that black mold causes asthma in people with no history of respiratory problems. However, those who currently are afflicted with asthma may experience a significant exacerbation of their symptoms if they are exposed to mold. Black mould has been known to produce symptoms consistent with asthma, including respiratory dysfunction. People with or without asthma who cough up blood may have been exposed to toxic mould.
Allergic reactions
Black mold has been the cause of numerous allergy-like symptoms in those who have been exposed to significant amounts. Irritable eyes, runny noses, scratchy throats, and dermatitis can occur in those who have inhaled mould. Those who experience a high fever or flu-like symptoms may also be manifesting symptoms of mold exposure. These symptoms will manifest with a suddenness and intensity not traditionally associated with the traditional flu virus.
Fungal infections
Fungal infections are the rarest reported symptom of mildew-related health problems, and tend to impact only those with compromised immune systems, including people undergoing chemotherapy. Those with the HIV/AIDS virus or exceptionally young children tend to exhibit fungal infections. Adults with healthy immune systems do not generally manifest fungal infections due to exposure. In some cases, infants have experienced a pulmonary hemorrhage or hemosiderosis as a result of mould exposure.
What are symptoms of black mold poisoning?
The symptoms of black mold poisoning vary from person to person and are also affected by how much you were exposed to.
Exposure typically causes effects characteristic of an allergic reaction or respiratory issues like asthma. Long-term contact is also linked to health risks like chronic respiratory and neurological issues. A recent study found that 93% of patients suffering from Chronic Fatigue Syndrome tested positive for the presence of mycotoxins in their bloodstreams. People who have an immunodeficiency or who suffer from certain illnesses like asthma, chronic obstructive pulmonary disorder (COPD) or where affected by the coronavirus are especially at risk to toxicity.

You may experience any of the symptoms below, either on their own or in combination with one another. Since many of these effects can be indicative of conditions or illnesses unrelated to toxic exposure, you should consult with your doctor for an accurate diagnosis and treatment plan.
- Red, itchy eyes
- Coughing, wheezing, shortness of breath, or sinus congestion
- Headaches, difficulty concentrating, confusion, forgetfulness, or brain fog
- Weakness, extreme tiredness
- Joint pain, aches, muscle cramping, or nerve pain
- Insomnia, depression, or anxiety
How is Mold Poisoning Treated
The effects of mold poisoning can be tricky to treat. Traditional treatments like antifungals do not work because in cases of fungal toxicity there is no actual fungal infection present within the body. Instead, it’s a matter of treating the effects while assisting your body to clear out the harmful toxins on its own.
The first and foremost step in treating fungal toxicity is to remove yourself from the harmful environment. Since mold poisoning is your immune system’s response to being exposed to the mycotoxins produced by black mold, the sooner you limit your contact, the better. This step will prevent your condition from worsening while you seek other forms of treatments in addition to preventing your symptoms from returning in the future.
The following medications can help you manage your respiratory-related symptoms:
- Antihistamines
- Nasal spray
- Allergy shots
Your body can also benefit from treatments that boost the immune system which will help your body to naturally filter out toxins more quickly and effectively. Be sure to consult with your doctor to put together a treatment plan that works best for you.
- Probiotics and antioxidants
- Limiting exposure to other toxins like pesticides and heavy metals
- Use of binding agents like charcoal and clay to prevent the toxins from re-circulating throughout the body
Long term effects / difficulty of concretely establishing causes
In some cases, experts believe that long term black mold exposure manifests as cancer. Again, because there is no one biomarker that helps identify the presence of black mold within the human body, this linkage is causal at best. Scientists know that mycotoxins are responsible for creating health problems in humans, among other creatures; but creating a solid cause/effect chart is difficult. Mycotoxins can immediately manifest harm, or lay dormant for years. Their ferocity is based on the relative state of the immune system of the person they encounter, along with a host of other as yet undefined factors.
Remove black mold after exposure
When confronted with black mold in your home, having the black mold removed is necessary to prevent further infestation and growth. Below are the steps and precautions outlined to perform a proper and safe black mold removal and cleanup job.
How to prevent black mold exposure?
Studies have shown that poor building standards can contribute to the presence of black mildew. Sick Building Syndrome, commonly known as SBS, is a term applied to structures which engender symptoms including fatigue, respiratory problems, dry coughing, and dermatitis.
These structures usually exhibit poor ventilation and/or chemical contamination, which can frequently lead to the growth and spread of black mold. In general, property owners should be careful not to purchase buildings which have poor ventilation, while tenants should avoid leasing properties which have poor air quality.
Additionally, any incidences of flooding or water damage should be addressed immediately with a thorough clean-up to prevent the growth of mould. If water pools for a significant amount of time, it can eventually cause the growth of black mold within the walls of the entire property.
When a heater or air conditioner is turned on after a long period of dormancy, the individual should allow the appliance to run for several minutes without breathing in any of the air. In many cases, long dormant appliances can discharge an initially high amount of mold spores into the air.
Property owners should perform a regularly scheduled series of checks for black mould near faucets, drains, and sinks, especially if a tenant or inhabitant of the property reports any of the symptoms listed above.
The growth of black mold is easy enough to prevent as long as buildings are kept free from water damage. However, mildew can grow in “dry” climates. Vigilance is the best method of preventing black mildew.
Comments are closed.